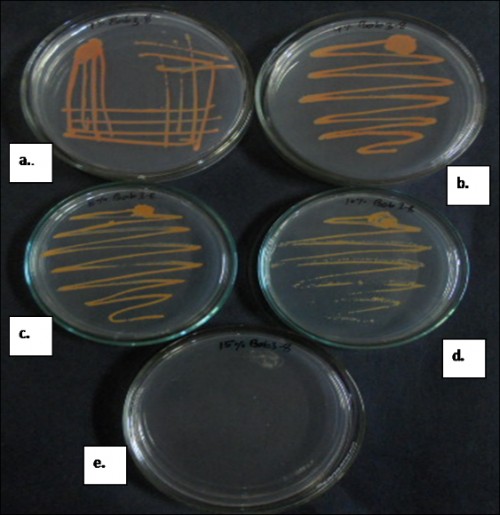

Isolation and characterization of Dietzia maris from midgut of Aedes albopictus: A suitable candidate for paratransgenesis
 Fig. 1:
Fig. 1: Purified culture of isolate a. on nutrient agar and b. in nutrient broth
 Fig. 2:
Fig. 2: Salt tolerance of bacterial strain
- a. at 1%, b. at 4%, c. at 8%, d. at 10% and e. at 15%
 Fig. 3:
Fig. 3: Scanning Electron Microscopy (SEM) image of Bacterial sample at 5000X magnification
 Fig. 4:
Fig. 4: (a)
Spectra generated by Microflex III mass spectrometer (b)
Identified by matching with
Biotyper database
 Fig. 5:
Fig. 5: Dendrogram based on 16S rRNA gene sequencing constructed by neighbor joining method using Kimura 2 distances parameter